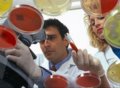
美科学家发现导致脱发蛋白质

|
美国研究员为受脱发困扰的男士带来佳音,他们发现一种皮层脂肪细胞可控制毛囊干细胞,从而刺激毛发生长,科学家希望利用干细胞技术解决秃头问题。 脱发是“男人最痛”之一,很多男士试尽所有方法,为求令头发“起死回生”。根据美国耶鲁大学研究员在《细胞》(Cell)杂志发表的研究,脱发人士的毛囊仍有头发生长所需的干细胞,但那些干细胞却停止活动,不能刺激头发生长,而毛囊内的干细胞需要一种讯号才会长出头发。 英国研究团队今天说,他们已经找到一种透过向细胞下指令以促进毛发生长的蛋白质“密码”,这项发现能协助治疗遗传性秃头。 英格兰西北部曼彻斯特大学的科学家说,透过向更多细胞传送密码,能够培育老鼠长出更多毛发,这项技术可能能够复制在人类身上。 曼彻斯特大学的一群研究人员近来公布,他们为帮助因外胚层发育异常而有毛发、皮肤、指甲、牙齿和汗腺不正常发展等遗传特征者所进行的一项研究,已发现能促使细胞长出毛发的蛋白质遗传密码,将使治疗遗传性秃头有突破性进展。 研究人员辨识出,在胚胎皮层生成时,这些在细胞外运作的某一种蛋白质分子是如交互作用,以致于影响毛发的生长型态。 乳清(Whey)是乳汁中酪蛋白凝结滤去后剩下的液体成分,一般是制作乳酪过程中的副产品。含有相当量的蛋白质和少量脂肪,以及乳糖、维生素和矿物质。 乳清可以加入其他食品如面包、饼干中来增加营养价值。也被用做动物饲料。乳清产品包括乳清乳酪、乳清粉、乳清蛋白。 中评社北京3月23日电/很多中年男性都担心自己脱发,有数据显示50岁的男性出现脱发的概率是50%,而随着年龄的增长,这一数据还会增加。 近日美国科学家表示,他们发现了阻止男性头发再生的一种蛋白质,而抑制该蛋白质的药物已在此前研发出来治疗哮喘症。目前科学家们正据此研究一种生发乳或者药剂,预计在5年内新药物将被推入市场。 分子生物學中蛋白質體學研究的新興與系統生物學,讓我們對於細胞發展的了解有明顯的增加,而且進步到可以控制細胞週期。在這個研究中,我們確定細胞激素角色的重要性。VEGF(血管內皮生長因子)在毛囊生命的發展中扮演一個重要的角色,不只起始生長,還有確定分化、結構與生長的時間長短。我們將探討以VEGF來治療掉髮的可行性,與是否可以做為一種在安全性與穩定性的疑慮上優於細胞激素治療的方法。 |
网站搜索
常用连结
|